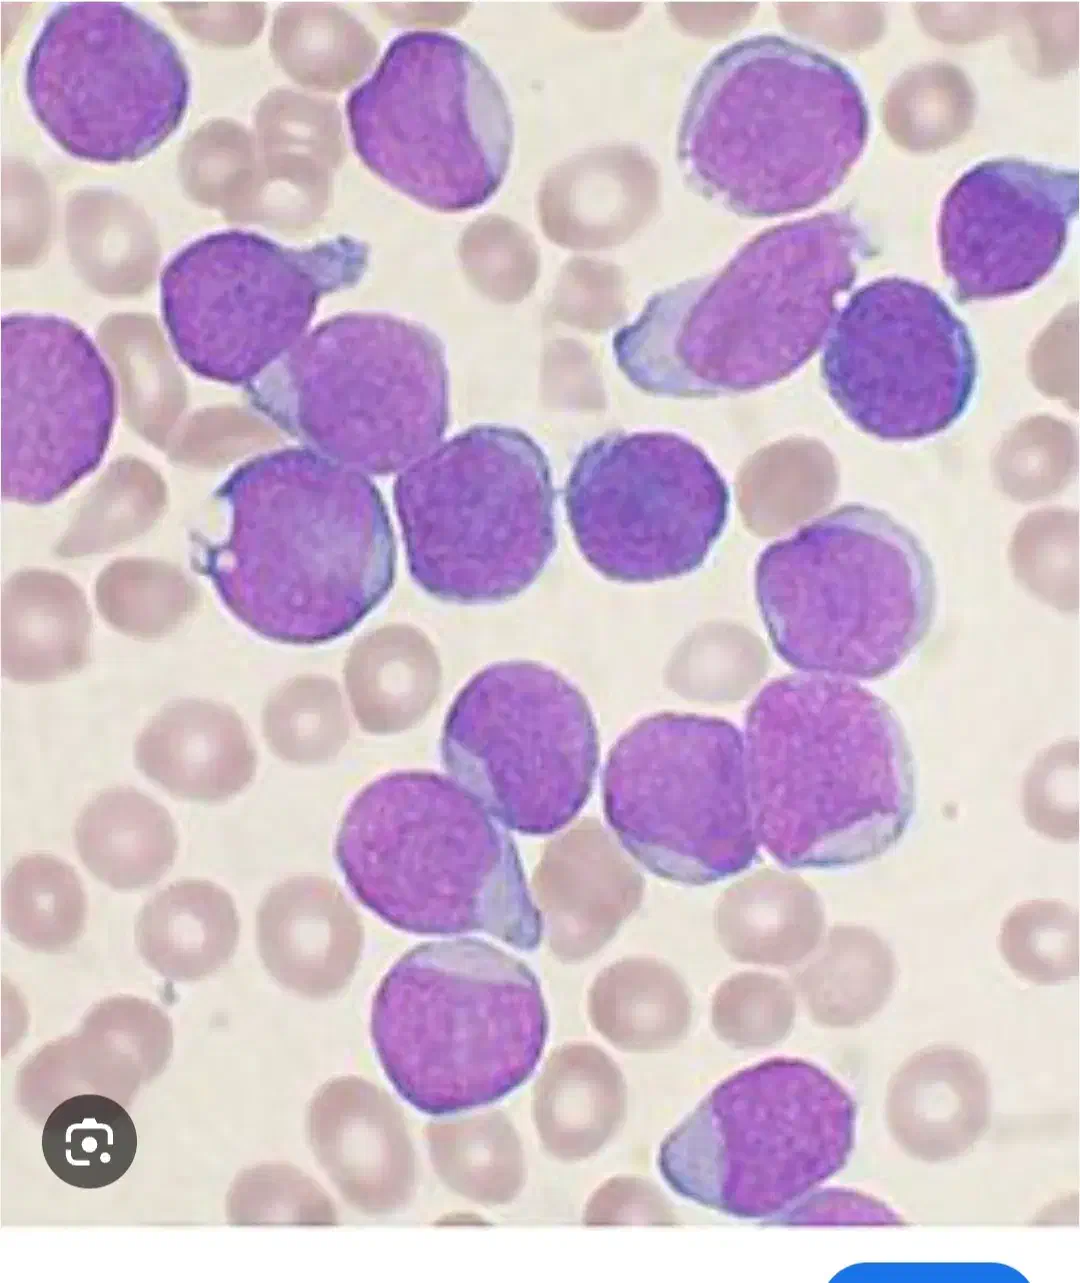
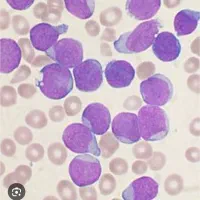

تدریس خصوصی هماتولوژی عملی با میکروسکوپ در منزل
هر روز از ساعت ۱۵ تا ۲۲ «حتی در روزهای تعطیل»
توضیحات
تدریس خصوصی هماتولوژی از ابتدا تا سطوح پیشرفته در منزل.با ۲۰ سال سابقه کار در هماتولوژی. اموزش دیف زدن انواع لامهای کم خونی و تالاسمی . تشخیص انواع سرطانها و بیماریها از روی لام خونی. جهت پیشرفت عملی دانشجویان و کارورزان و شاغلین محترم ازمایشگاهها.
یادداشت تنها برای شما قابل دیدن است و پس از حذف آگهی، پاک خواهد شد.